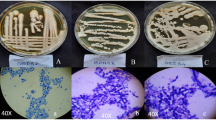

Abstract
In this study, we explored the multiple heavy metal-resistant yeast isolated from heavy metal-polluted environment. The isolated yeast showed maximum growth at 30 °C, pH 7.0, and the strain was identified as Candida tropicalis through 18S ribosomal RNA (rRNA) gene sequence analysis. Yeast cells grew well in medium containing different concentrations of heavy metal ions [CdCl2, Pb(NO3)2, NaAsO2, CuSO4 and K2Cr2O7]. Minimum inhibitory concentration (MIC) against different metal ions was ranged from 5 to 19 mM, and the metal resistance value against each metal observed by yeast cells was 5 mM (Cr), 10 mM (Cd), 15 mM (As), 14 mM (Cu) and 19 mM (Pb) and increased in the following order: Pb > Cu > As ≥ Cd > Cr. The total cellular glutathione, GSH/GSSG redox couple and metallothioneins like protein (MT) were assayed by growing cultures for 24 h and exposed to 100 mg/L of each heavy metal ion. Remarkable increase in γ-glutamylcysteinylglycine (GSH) level was determined in arsenic and cadmium treatment followed by chromium, lead and copper. Stressed cells had much more oxidized GSH than unstressed cells. GSH/GSSG ratio was significantly increased in cadmium and copper treatment in contrast to chromium, arsenic and lead. Statistical analysis revealed significantly higher cysteine level in all metal-treated samples as compared to control. Antioxidant glutathione transferase activity was not detected in metal-treated and untreated yeast samples. One-dimensional electrophoresis of proteins revealed marked differences in banding pattern of heavy metal-exposed yeast samples. A prominent 20 kDa band was observed in all treated samples suggesting that some differential proteins could be over-expressed during heavy metal treatment and might be involved in cell resistance mechanisms.
Similar content being viewed by others
Explore related subjects
Discover the latest articles, news and stories from top researchers in related subjects.Avoid common mistakes on your manuscript.
Introduction
Candida tropicalis has been identified as the most prevalent emerging pathogenic yeast and infections due to C. tropicalis that have dramatically increased on a global scale (Kothavade et al. 2010). Yeast has known to be a potential for the removal of heavy metal cations from aqueous solutions (Blackwell et al. 1995). Like other yeast species, C. tropicalis can accumulate cadmium, lead and other heavy metal ions. Heavy metal-induced oxidative stress can adversely affect cell’s DNA, RNA, ribosome synthesis and enzyme systems.
The tripeptide γ-glutamylcysteinylglycine (GSH) is the most abundant low molecular weight sulphur-containing compound in eukaryotes. It has proposed roles in detoxification of xenobiotics, carcinogens and ROS oxidative stress produced by reactive oxygen species (ROS). It also plays numerous functions in protection, transport and enzymatic catalysis (Penninckx 2002; Kim et al. 27005). GSH biological importance is dependent on the redox-active sulfhydryl moiety of its cysteine residue which can act as a free radical scavenger. GSH is involved in the oxidative stress (OS) response by reacting with oxidative agent resulting in GSSG. Living cells must maintain an intracellular reduced state against an external oxidizing environment, and this redox status is principally decided by the reduced (GSH) to oxidized (GSSG) glutathione ratio (Sies 1999; Schafer and Buettner 2001; Filomeni et al. 2002). If GSH/GSSG ratio favours GSSG, apoptosis may be triggered (Suzuki et al. 1998; Matés and Sánchez-Jiménez 2000). Rehman et al. (2007) reported that C. tropicalis culture containing Cu2+ (100 mg/L) could decline to 74 % copper after 96 h. In this study, we investigated heavy metal responses to glutathione and cysteine level in C. tropicalis and this study clearly demonstrate that induced oxidative stress in yeast could cause toxicity.
Materials and reagents
Chemicals used
Glutathione and cysteine estimation was performed by using Ellman’s reagent (5,5′-dithiobis-(2-nitrobenzoic acid)) or DTNB, reduced glutathione (GSH), oxidized glutathione (GSSG), cysteine (Cys), nicotinamide adenine dinucleotide phosphate (NADP+), NADPH, ethylenediamine-tetraacetic acid (EDTA), bovine serum albumin (BSA), sulfosalicylic acid, ferrous sulphate, ammonium sulphate, trichloroacetic acid (TCA), phosphate buffered saline (PBS), acrylamide and all general chemicals suitable for electrophoresis. Metal ions used for producing oxidative stress were CdCl2, NaAsO2, CuSO4, Pb (NO3)2 and K2Cr2O7. Stock (1 M) of each heavy metal was prepared in deionized water whereas DTNB stock was made in ethanol and of GSH in 0.1 % HCl aqueous solution.
Culturing and handling procedures
Organisms were sampled from industrial effluent of Shiekhupura located near Lahore, and samples were collected in sterilized containers and afterwards spread on YPD [2 % glucose, 1 % yeast extract, 2 % bacto-peptone and 2 % agar (pH 6.5)] agar plates used for storing and cultivating. Single colonies were selected for culture in YPD broth under controlled condition of temperature (30 °C). Screening and selection were done in the presence of heavy metal ions such as CdCl2, NaAsO2, K2Cr2O7, CuSO4 and Pb (NO3)2 in liquid salt medium containing 1 % glucose, 0.1 % (NH4)2SO4, 0.015 % KH2PO4, 0.01 % K2HPO4, 0.01 % MgSO4·7H2O, 0.0026 % FeSO4, 0.0086 % CaCl2 (pH 7.0–7.2) and 1 % glucose with constant shaking incubation (120 rpm) for 24 h at 30 °C. Salts of heavy metals ions [CdCl2, NaAsO2, CuSO4, Pb (NO3)2 and K2Cr2O7] were added to yeast culture after 24 h of incubation.
Determination of MIC
The minimum inhibitory concentration (MIC) of each heavy metal ion treatment was determined at 30 °C for C. tropicalis against increasing concentrations of CdCl2, NaAsO2, CuSO4, Pb (NO3)2 and K2Cr2O7 on YPD agar plates. The initial metal concentration used was 0.1 mM prepared from 1 M stock solution. Grown yeast cells were subsequently transferred at a given concentration to the next concentration, and maximum resistance was evaluated until the strain was unable to grow colonies on agar plates. Growth curves, pH and temperature were also assessed.
Molecular identification of yeast strain
DNA was isolated according to Masneuf-Pomarède et al. (2007), and 18S ribosomal RNA (rRNA) gene was amplified by polymerase chain reaction (PCR) using two oligonucleotide yeast 18S rRNA primers, the forward primer (ITS5; 5-GGAAGTAAAAGTCGTAACAACG-3) and the reverse primer (ITS-4; 5-TCCTCCGCTTATTGATATGC-3). PCR was preceded at 94 °C for 4 min, annealing at 55 °C for 2 min and elongation at 72 °C for 10 min. The gene was cleaned by the thermo scientific geneJET gel extraction kit method. PCR product was analyzed by 1.5 % (w/v) agarose gel electrophoresis in 1× TAE buffer with ethidium bromide (0.5 μg/ml).
Protein extraction and measurement
Yeast cell culture was centrifuged at 1400g for 10 min, collected pellet (fresh weight) washed twice with phosphate buffered saline (PBS; pH 7) and mixed in extraction buffer. Cells were sonicated for 15 s with 60 s interval (5 cycles) and centrifuged at 11,000g (4 °C) for 10 min. Sample protein concentration was measured by Bradford method with bovine serum albumin (BSA) as a standard (Bradford 1976). Protein extracts were stored at −80 °C until used for further biochemical analysis.
One-dimensional gel electrophoresis
One-dimensional (1-DE) gel electrophoresis was performed on 14 % polyacrylamide gels. Protein extracts (20 μg) were precipitated with an equal volume of 10 % chilled TCA (v/v) and centrifuged at 11,000g for 15 min. Protein extracts were further solubilized in sample buffer and electrophoresed at a constant voltage of 90 V for 90 min and 120 V afterwards until the end of the gel according to Laemmli (1970).
Reduced/oxidized glutathione and cysteine assay
GSH and non-protein thiol contents in cell lysates were estimated by the chemical method previously described by Israr et al. (2006). MSM broth medium (100 ml) was taken in 250 ml flask labelled as control and treatment, inoculated with 5 × 106/ml of fresh pre-culture yeast cells and incubated on shaker with constant agitation (120 rev/min.) at 30 °C. GSH levels were determined following 48 h treatment with oxidants, and the cells were harvested by centrifugation. Collected pellet (fresh weight) was washed twice with 1 mM phosphate buffered saline (pH 7.4) to remove any traces of growth medium, weighed and suspended in 5 % sulfosalicylic acid. Cells were sonicated for 15 s with 60 s interval (5 cycles) and afterwards centrifuged at 1500g for 10 min at 4 °C. The suspension obtained was used to assess glutathione and non-protein thiol levels.
GSH and GSSG levels were quantified by incubating the reaction mixture that contained reaction buffer [0.1 M phosphate buffer (pH 7); 0.5 mM EDTA], crude extract or lysate and 3 mM of 5 dithio-bis-(2 nitrobenzoic acid) at 30 °C for 5 min followed by addition of NADPH (0.4 mM) and 2-μl glutathione reductase (GR) enzyme. Samples were kept for another 20 min to allow the reaction to complete and absorbance was taken at 412 nm. GSH levels in the samples were compared with standard curve constructed by using various concentrations of reduced glutathione (GSH). GSH levels are expressed as micrmolar of GSH per gram of cells. Yeast cells prepared from oxidant-free salt medium was taken as control. Cysteine and non-protein thiols were quantified by mixing 100 μl yeast sample (treated and untreated), 1 mM of 5 dithio-bis-(2-nitrobenzoic acid) and 0.1 M reaction buffer, and the reaction was completed by incubating reaction mixture at 30 °C for 10 min. A standard curve was prepared from varying concentrations of cysteine to calculate the non-protein thiol contents in samples.
Glutathione transferase assay
Glutathione transferase (GST) was determined by Habig et al. (1974). The reaction mixture contained substrate for GSH: 1 mM 1-chloro-2, 4-dinitrobenzene (CNDB), 1 mM reduced GSH in 150 mM phosphate buffer (pH 6.5) and enzyme extract. The formation of S-2, 4-dinitrophenyl glutathione conjugate was followed as an increase in absorbance at 340 nm (every 20 or 30 s) for 5 min.
Statistical analysis
Three independent experiments were performed, and data shown in this study was average values of means ± standard deviation (SD). Significance testing between samples was calculated by performing Student’s t test, and analysis was done with the program statistical package for social sciences (SPSS) version 15. Control groups were treated identically but not exposed to any treatment.
Results
Molecular identification of yeast isolate
In this study, heavy metal-resistant yeast that adapted various stress resistance mechanisms was isolated from metal-polluted wastewater site (Rehman and Anjum 2011). Growth rate of the yeast isolate in the presence of heavy metal (Cd, As, Cu, Cr and Pb) was consistently slower than that of the control, and comparable results have been reported earlier (Pal et al. 2004; Edward Raja et al. 2006). Slow growth of Candida intermedia strain was observed at 50 mg/L copper with extended lag growth phase (Fujs et al. 2005). Mozafar et al. (2002) reported that the number of spores of arbuscular mycorrhizal (AM) fungi was greatly affected and reduced in the presence of heavy metal ions.
The BLAST analysis of 18S rRNA gene sequence of the strain showed 100 % homology to already reported C. tropicalis. The nucleotide sequences coding for C. tropicalis have been submitted to GenBank database under accession number JN009853.
Determination of MIC
The MIC of the yeast isolate was ranged from 3 to 20 mM, and the metal resistance values were 5 mM (Cr), 10 mM (Cd), 15 mM (As), 14 mM (Cu) and 19 mM (Pb). This higher degree of resistance to heavy metal ions that showed tolerance trend was in the order Pb > Cu > As ≥ Cd > Cr. Among the heavy metals, chromium showed toxicity to higher extent whereas lesser toxicity was seen in lead- and arsenic-treated yeast samples. Berdicevsky et al. (1993) reported that C. tropicalis revealed high levels of resistance to water-soluble ions such as Hg, Pb, Cd, arsenate (AsO4) and selenite (SeO3). Li and Yuan (2006) reported that Rhodotorula sp. Y11 was resistant, and highest metal uptake value obtained was 19.38 mg/g by boiling treated yeast cells. Recently, Ilyas et al. (2014) have isolated a metal-resistant fungus, Trichosporon asahii, that can tolerate NaAsO2 (30 mM) and CdCl2 (10 mM). Moreover, Balsalobre et al. (2003) implied that the tolerance and capacity of uptake towards metals are dependent on ionic metal and yeast species.
Measurement of GSH, GSSG and non-protein thiols
Cellular GSH and GSSG levels in C. tropicalis were altered on heavy metal exposure mainly due to oxidation, degradation or reaction of GSH with other proteins. Yeast cells grown were survived well in 100 mg/L of CdCl2, NaAsO2, CuSO4, Pb (NO3)2 and K2Cr2O7 which corresponded to doses of 550 μM (Cd), 770 μM (As), 626 μM (Cu), 302 μM (Pb) and 340 μM (Cr). A remarkable 2-fold increase in reduced GSH intracellular pool was observed in NaAsO2- and CdCl2-treated cells. A recent report in Saccharomyces cerevisiae showed that arsenite challenge increased GSH biosynthesis (Thorsen et al. 2007). Likewise, Fauchon et al. (2002) reported that cadmium strongly enhances intracellular GSH content and optimizes cadmium detoxification process (Li et al. 1997; Vido et al. 2001; Lafaye et al. 2005; Gharieb and Gadd 2004). One and a half fold increment was observed under K2Cr2O7 and CuSO4 stress which decreased up to one half fold after Pb(NO3)2 treatment (Table 1). Previous studies have been revealed that increasing GSH synthesis through overexpression of GSH1 augments the GSH pool by 50–66 % (Grant et al. 1997; Cuozzo and Kaiser 1999), and various metabolic processes lead to induction of enzymes involved in the GSH pathway (Fauchon et al. 2002; Vido et al. 2001). The rise in regeneration and accumulation of GSH in response to oxidative stress could be a significant determinant of cell survival. Under oxidative stress, GSH depletion can lead to protein denaturation, potential loss in protein function and aggregation subsequent to protein thiol oxidation (Freeman et al. 1997). GSSG is potentially toxic to the cells and was detected at very low concentration in unstressed cells than in stressed cells (Table 1). A significant increase in the GSSG level was observed in NaAsO2, K2Cr2O7 and Pb(NO3)2 treatments that was unaffected or not fluctuated much in CdCl2- and CuSO4-treated cells. GSSG could react with a protein thiol to produce a protein-mixed disulphide (PSSG) which can further exchange with another protein thiol to a protein disulfide (Huang and Huang 2002). The formation of PSSG is long-lasting throughout oxidative stress.
Taking into account the total GSH concentration, NaAsO2 showed the highest 2.7-fold increase whilst a 2-fold increase in CdCl2- and K2Cr2O7-treated yeast cells was shown compared to wild-type cells (Fig. 1). Metals like CuSO4 and Pb (NO3)2 displayed a decline in total GSH intracellular level when compared to other heavy metal ions presumably as a result of GSH degradation. Redox ratio (GSH/GSSG) in a cell gives a degree of the amount of GSH present in oxidized state relative to reduced state. The GSH/GSSG ratio was consistently higher in CdCl2- and CuSO4-treated cells which is in agreement with the findings of Pena-Llopis et al. (2002). In contrast, the ratio was declined significantly (p < 0.05) in Pb (NO3)2-, NaAsO2- and K2Cr2O7-treated yeast cells (Fig. 2). S. cerevisiae mutants for yap1 have previously been reported to decrease the GSH/GSSG ratio on exposure to arsenic (Menezes et al. 2008; Gardiner and Reed 1994). Reduced or increased GSH redox ratio indicated that heavy metal ions had shifted the redox balance of the cell to more oxidized or reduced states and is an extremely sensitive measure for determining the cellular redox status. The most significant effect (2.5-fold) on the production of cysteine and non-protein thiols by K2Cr2O7-treated cells was detected that was doubled in CdCl2- and CuSO4-treated yeast cells. Almost one half fold increase was detected in Pb (NO3)2, and a lowest rise (one quarter) was seen in NaAsO2 treatment (Fig. 3). No antioxidant GST activity was detected in control and all treated samples. These results are in contrast with the reports of Sheehan and Casey (1993) and Kumagai et al. (1988).
One-dimensional gel electrophoresis-based assay
One-dimensional (1-DE) gel electrophoresis was performed for exploring the expression of proteins extracted from metal-treated and untreated yeast cells. Protein of known concentrations (20 μg) was used, and most of the differentially expressed protein bands were seen in yeast samples exposed to heavy metals. Banding pattern of proteins revealed different intensities between control and treatments, although overall protein loadings were comparable (Fig. 4).
One-dimensional (1-DE) gel electrophoresis of proteins extracted from C. tropicalis. Sample proteins (20 μg loading) were homogenized in sample buffer and run for 30 min at 90 V followed by 120 V. Gels were stained with Coomassie Brilliant Blue R-250 for 40 min. Lane M molecular mass of maker, lane 1 control, lane 2 NaAsO2, lane 3 CuSO4 and lane 4 K2Cr2O7
In cadmium and copper, the 80 and 30 kDa protein band was much weaker as compared to control. A prominent 20 kDa protein band was observed in all heavy metal-treated samples when compared to control. Low molecular weight proteins were also abundant in metal-treated samples implying the possible role of metallothioneins (MT) in protection and survival of yeast strain against metal oxidative stress. Certain bands appeared in treatments were absent in control, especially lower molecular weight proteins in the mass range of <20 kDa with increased intensity observed in heavy metal-treated samples.
References
Balsalobre, L., De-Siloniz, M. I., Validerrama, M. J., Benito, T., Larrea, M. T., & Peinado, J. M. (2003). Occurrence of yeasts in municipal wastes and their behaviour in presence of cadmium copper and zinc. Journal of Basic Microbiology, 43, 185–193.
Berdicevsky, I., Duek, L., Merzbach, D., & Yannai, S. (1993). Susceptibility of different yeast species to environmental toxic metals. Environmental Pollution, 80(1), 41–44.
Blackwell, K. J., Singlenton, I., & Tobin, J. M. (1995). Metal cation uptake by yeast: a review. Applied Journal of Microbiology and Biotechnology, 43, 579–584.
Bradford, M. M. (1976). Rapid and sensitive method for the quantitation of microgram quantities of protein utilizing the principle of protein-dye binding. Analytical Biochemistry, 72, 248–254.
Cuozzo, J. W., & Kaiser, C. A. (1999). Competition between glutathione and protein thiols for disufide bond formation. Nature Cell Biology, 1, 130–135.
Edward Raja, C., Anbazhagan, K., & Selvam, G. S. (2006). Isolation and characterization of a metal resistant Pseudomonas aeruginosa strain. World Journal of Microbiology and Biotechnology, 22, 577–586.
Fauchon, M., Lagniel, G., Aude, J. C., Lombardia, L., Soularue, P., Petat, C., Marguerie, G., Sentenac, A., Werner, M., & Labarre, J. (2002). Sulfur sparing in the yeast proteome in response to sulfur demand. Molecular Cell, 9, 713–723.
Filomeni, G., Rotilio, G., & Ciriolo, M. R. (2002). Cell signalling and the glutathione redox system. Biochemical Pharmacology, 64, 1057–1064.
Freeman, M. L., Huntley, S. A., Meredith, M. J., Senisterra, G. A., & Lepock, J. (1997). Destabilization and denaturation of cellular protein by glutathione depletion. Cell Stress and Chaperones, 2, 191–198.
Fujs, S., Gazdag, Z., Poijsak, B., Stibilj, V., Milacic, R., Pesti, M., Raspor, P., & Batic, M. (2005). The oxidative stress response of the yeast Candida intermedia to copper, zinc, and selenium exposure. Journal of Basic Microbiology, 45, 125–135.
Gardiner, C. S., & Reed, D. J. (1994). Status of glutathione during oxidant-induced oxidative stress in the pre implantation mouse embryo. Biology of Reproduction, 51, 1307–1314.
Gharieb, M. M., & Gadd, G. M. (2004). Role of glutathione in detoxification of metal (loid)s by Saccharomyces cerevisiae. Biometals, 17, 183–188.
Grant, C. M., MacIver, F. H., & Dawes, I. W. (1997). Glutathione synthetase is dispensable for growth under both normal and oxidative stress conditions in the yeast Saccharomyces cerevisiae due to an accumulation of the dipeptide-glutamylcysteine. Molecular Biology of the Cell, 8, 1699–1707.
Habig, W. H., Pabst, M. J., & Jakoby, W. B. (1974). Glutathione S-transferases. The first enzymatic step in mercapturic acid formation. Journal of Biological Chemistry, 249, 7130–7139.
Huang, K. P., & Huang, F. L. (2002). Glutathionylation of proteins by glutathione disulfide S-oxide. Biochemical Pharmacology, 64(5–6), 1049–1056.
Ilyas, S., Rehman, A., Varela, A. C., & Sheehan, D. (2014). Redox proteomics changes in the fungal pathogen Trichosporon asahii on arsenic exposure: identification of protein responses to metal-induced oxidative stress in an environmentally-sampled isolate. PloS One, 9(7), e102340.
Israr, M., Sahi, S. V., & Jain, J. (2006). Cadmium accumulation and antioxidant responses in the Sesbania drummondii callus. Archives of Environmental Contamination and Toxicology, 50, 121–127.
Kim, H. S., Kwack, S. J., & Lee, B. M. (2005). Alteration of cytochrome P-450 and glutathione S-transferase activity in normal and malignant human stomach. Journal of Toxicology and Environmental Health, 68, 1611–1620.
Kothavade, R. J., Kura, M. M., Valand, A. G., & Panthaki, M. H. (2010). Candida tropicalis: its prevalence, pathogenicity and increasing resistance to fluconazole. Journal of Medical Microbiology, 59(8), 873–880.
Kumagai, H., Tamaki, H., Koshino, Y., Suzuki, H., & Tochikura, T. (1988). Distribution, formation and stabilization of yeast glutathione S-transferase. Agricaltural and Biological Chemistry, 52,1377–1382.
Laemmli, U. K. (1970). Cleavage of structural proteins during assembly of the head of the bacteriophage T4. Nature, 227, 680–685.
Lafaye, A., Junot, C., Pereira, Y., Lagniel, G., Tabet, J. C., Ezan, E., & Labarre, J. (2005). Combined proteome and metabolite-profiling analyses reveal surprising insights into yeast sulfur metabolism. Journal of Biological Chemistry, 280, 24723–24730.
Li, Z. J., & Yuan, H. L. (2006). Characterization of cadmium removal by Rhodotorula sp Y11. Applied Journal of Microbiology and Biotechnology, 73, 458–463.
Li, Z. S., Lu, Y. P., Zhen, R. G., Szczypka, M., Thiele, D. J., & Rea, P. A. (1997). A new pathway for vacuolar cadmium sequestration in Saccharomyces cerevisiae: YCF1-catalyzed transport of bis(glutathionato)cadmium. Proceedings of National Academy of Sciences USA, 94, 42–47.
Masneuf-Pomarède, I., Le Jeune, C., Durrens, P., Lollier, M., Aigle, M., & Dubourdieu, D. (2007). Molecular typing of wine yeast strains Saccharomyces bayanus var. uvarum using microsatellite markers. Systematic and Applied Microbiology, 30(1), 75–82.
Matés, J. M., & Sánchez-Jiménez, F. M. (2000). Role of reactive oxygen species in apoptosis: implications for cancer therapy. The International Journal of Biochemistry & Cell Biology, 32(2), 157–170.
Menezes, R. A., Amaral, C., Batista-Nascimento, L., Santos, C., Ferreira, R. B., Devaux, F., Eleutherio, E. C., & Rodrigues-Pousada, C. (2008). Contribution of Yap1 towards Saccharomyces cerevisiae adaptation to arsenic-mediated oxidative stress. Journal of Biochemistry, 414, 301–311.
Mozafar, A., Ruh, R., Klingel, P., Gamper, H., Egli, S., & Frossard, E. (2002). Effect of heavy metal contaminated shooting range soils on mycorrhizal colonization of roots and metal uptake by leek. Environmental Monitoring and Assessment, 79(2), 177–191.
Pal, A., Choudhuri, P., Dutta, S., Mukherjee, P. K., & Paul, A. K. (2004). Isolation and characterization of nickel-resistant microflora from serpentine soils of Andaman. World Journal of Microbiology and Biotechnology, 20(9), 881–886.
Pena-Llopis, S., Ferrando, M. D., & Pena, J. B. (2002). Impaired glutathione redox status is associated with decreased survival in two organophosphate-poisoned marine bivalves. Chemosphere, 47(5), 485–497.
Rehman, A., & Anjum, M. S. (2011). Multiple metal tolerance and biosorption of cadmium by Candida tropicalis isolated from industrial effluents: glutathione as detoxifying agent. Environmental Monitoring and Assessment, 174, 585–595.
Penninckx, M. J., (2002). An overview on glutathione in Saccharomyces versus non-conventional yeasts. FEMS Yeast Research, 2(3), 295–305
Rehman, A., Farooq, H., & Shakoori, A. R. (2007). Copper tolerant yeast, Candida tropicalis, isolated from industrial effluents: its potential use in wastewater treatment. Pakistan Journal of Zoology, 39(6), 405.
Schafer, F. Q., & Buettner, G. R. (2001). Redox environment of the cell as viewed through the redox state of the glutathione disulfide/glutathione couple. Free Radical Biology and Medicine, 30, 1191–1212.
Sheehan, D., & Casey, J. P. (1993). Evidence for Alpha and Mu class glutathione S-transferases in a number of fungal species. Comparative Biochemistry and Physiology Part B: Comparative Biochemistry, 104(1), 7–13.
Sies, H. (1999). Glutathione and its role in cellular functions. Free Radical Biology and Medicine, 27, 916–921.
Suzuki, Y., Ono, Y., & Hirabayashi, Y. (1998). Rapid and specific reactive oxygen species generation via NADPH oxidase activation during Fas-mediated apoptosis. FEBS Letters, 425(2), 209–212.
Thorsen, M., Lagniel, G., Kristiansson, E., Junot, C., Nerman, O., Labarre, J., & Tamas, M. J. (2007). Quantitative transcriptome, proteome and sulfur metabolite profiling of the Saccharomyces cerevisiae response to arsenite. Physiological Genomics, 30, 35–43.
Vido, K., Spector, D., Lagniel, G., Lopez, S., Toledano, M. B., & Labarre, J. (2001). A proteome analysis of the cadmium response in Saccharomyces cerevisiae. Journal of Biological Chemistry, 276, 8469–8474.
Conflict of interest
We declare that we have no conflict of interest.
Author information
Authors and Affiliations
Corresponding author
Rights and permissions
About this article
Cite this article
Ilyas, S., Rehman, A. Oxidative stress, glutathione level and antioxidant response to heavy metals in multi-resistant pathogen, Candida tropicalis . Environ Monit Assess 187, 4115 (2015). https://doi.org/10.1007/s10661-014-4115-9
Received:
Accepted:
Published:
DOI: https://doi.org/10.1007/s10661-014-4115-9